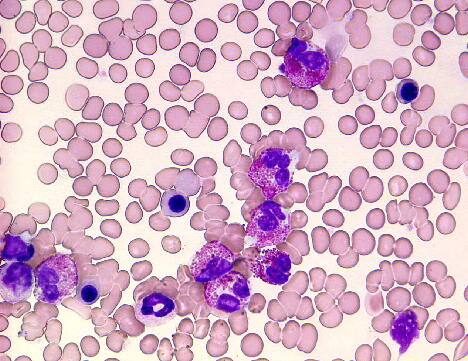

腸の病気の原因
「あなたも好酸球性胃腸炎では」
一昨日は、北海道のAさんから電話で、すっかり良くなったとのこと。
過去2回電話相談をしたのですが、
一回目が5月末。
病気というほどではないものの胃腸の具合がいつも悪く、
下痢・便秘を繰り返し、
腹部膨満感が常にあり、ガスも頻繁に出る。
でも食欲が落ちるわけでもなく、体重が減るわけでもないということで、
今まで、乳酸菌を試したり、断食をやってみたり、
いろんなことをやったが改善されないとのこと。
その時は、胃腸全般へのパワーと、
蠕動運動が高まるパワーを入れたのです。

で、6月末に2回目の電話相談をやったのですが、
ほとんど改善されなかったとのこと。
そこで、アレルギー・自己免疫・その他に絞ってYES/NOでみた所、
アレルギーの可能性が断トツ。
聞けば、幼児のころに蕁麻疹をやり、
その後、足にいぼがイッパイだったとのこと。
それがしばらく落ち着いていたのですが、
思春期の頃また蕁麻疹が再発、
毎回町医者に通い、薬(プレドニゾロン錠5㎎?)をもらっていたとのこと。
で、お腹の方はいつごろからかというと、
30代前位からとのこと。
そこで、前回、アレルギーのパワ―を強力に送ったところ、
最初の2・3日でみるみる改善されたとのことでした。

(出典:http://wajifudou.blog.so-net.ne.jp/2016-01-20)
結局、アレルギー体質の方は、
皮膚や呼吸器などに出ると深刻なので問題視されるのですが、
それらがいったん沈静化しても体質そのものは変わらず、
多くの場合軽い胃腸障害など、
病院へ行っても対処してくれない「不定愁訴」とされるのです。
でも、ご本人的にはなかなかつらく、
血液所見では好酸球の増多が認められるので、
「好酸球性胃腸炎」などと呼ばれます。
でも、そこまで行かないのを「過敏性大腸炎」といい、
特段の血液所見は無いとされるのですが、
こうした人たちが病院へ行くのは、かなり末期的状況で、
白血球右方移動のため、好酸球が検出されないのだと考えられます。
Aさんもついこないだまで、
「食生活がイヤしい」のではとか、「お酒が良くないのか」、
また、「食べすぎか」など、
自分の生活上の不注意に原因があるのかと思っておられたようですが、
真面目で典型的な日本人なのでしょう。
実際、好酸球性胃腸炎は日本人に多く
戦後の急激な食生活の欧米化が、
原因の一端となっているのかもしれません。
病気とまでは言えない胃腸の問題、
あなたの場合もアレルギーを疑ってみたら・・